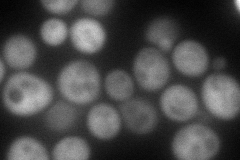
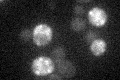

View description
Ubiquitin-specific protease that removes ubiquitin from ubiquitinated proteins; interacts with Rsp5p and is required for MVB sorting of membrane proteins; can cleave polyubiquitin and has isopeptidase activity
Localization:
Intensity:
Fold change:
Significance:
-
C’ GFP library in SD

below threshold15.92 -
N' NOP1pr-GFP in SD

cytosol139.565 -
N' TEF2pr-mCherry in SD
cytosol165.683 -
N' NATIVEpr-GFP in SD

cytosol45.6652 -
N' TEF2pr-VC and Cyto-VN in SD

#N/A0 -
C’ GFP library in SD+DTT

cytosol15.240.95No -
C’ GFP library in SD+H2O2

cytosol18.461.15No -
C’ GFP library in Starvation Media
cytosol16.61.04No -
C’ GFP library on the background of Pup2-DaMP

below threshold -
C’ GFP library on the background of CCT mutant

below threshold17.69151.1104No
